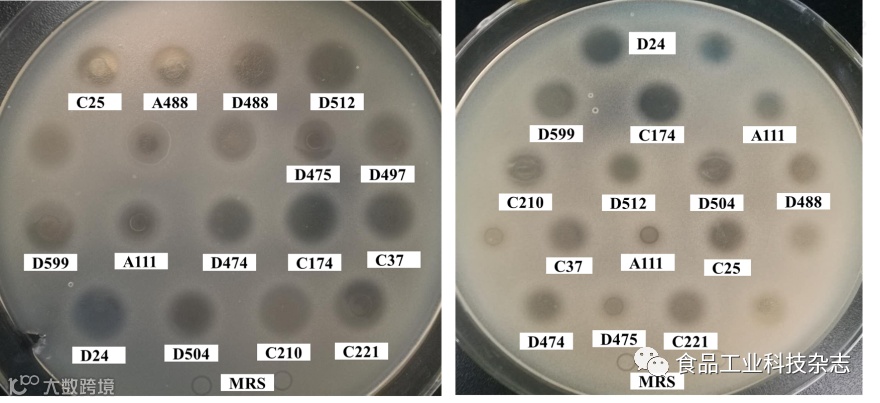

益生菌对2型糖尿病小鼠的调节作用
白璐,张喆,梁曦,吕优优,周慧,张峻雪,易华西,刘同杰,公丕民,冯丽荣,冷友斌*,张兰威*
知网首发链接:
http://kns.cnki.net/kcms/detail/11.1759.TS.20200428.0928.002.html


菌株表面疏水性和自聚能力的比较
Comparison of surface hydrophobicity and self-aggregation ability of the strains
注:不同小写字母表示不同菌株间差异显著,P<0.05。
益生菌发酵代谢蓝莓花色苷的规律研究
陶阳,廖小军*,韩永斌
知网首发链接:
http://kns.cnki.net/kcms/detail/11.1759.TS.20200304.2113.013.html

发酵过程中三种益生菌菌落总数变化情况
Changes in total number of colonies in cultivation medium during probiotic fermentation
注:LP,SQ和ST分别代表植物乳杆菌、两岐双歧杆菌和嗜热链球菌。
益生菌发酵牦牛肉血肠的制作工艺优化
贡佳欣,唐善虎*,李思宁,陈一萌,李琦
食品工业科技, 2020, 41(9): 41-48.
doi:10.13386/j.issn1002-0306.2020.09.007
官网链接:http://www.spgykj.com/PDF-nwe/2020/2020.9/20-9-41.pdf
益生菌中药的研究现状及产品开发
王静涵,张斯童,腾利荣,王真慧,王刚,孙旸,陈欢*,陈光*
食品工业科技, 2020, 41(14): 337-343, 348
doi:10.13386/j.issn1002-0306.2020.14.054
官网链接:http://www.spgykj.com/PDF-nwe/2020/2020.14/20-14-337.pdf
请输入标题复合益生菌协同的发酵葡萄汁菌种筛选与工艺优化
仵白敏,杨文博,刘慧,张春岭,刘杰超,焦中高*
食品工业科技, 2020, 41(13): 122-127.
doi:10.13386/j.issn1002-0306.2020.13.020
官网链接:http://www.spgykj.com/PDF-nwe/2020/2020.13/20-13-122.pdf

不同益生菌在葡萄汁中的生长及发酵曲线
Growth curves of different probiotic strains in grape juice
请输入标题一种百岁老人源罗伊氏乳杆菌益生特性及其发酵水牛乳制备工艺优化
孙荟,兰海静,梁晓琳,黄联莉,韦子龙,李全阳*
食品工业科技, 2019, 40(17): 90-96.
doi:10.13386/j.issn1002-0306.2019.17.015
官网链接:http://www.spgykj.com/PDF-nwe/2019/2019.17/19-17-90.pdf

温度对感官评分和益生菌数的影响
Effects of temperature on sensory scores and probiotic counts
益生菌缓解肥胖形成相关机制及研究进展
陆婧婧,王娜娜,焦文姝,霍贵成*
食品工业科技, 2019, 40(3): 296-299, 306.
doi:10.13386/j.issn1002-0306.2019.03.047
知网首发链接:
https://kns.cnki.net/KCMS/detail/detail.aspx?dbcode=CJFQ&dbname=CJFDLAST2019&filename=SPKJ201903047&uid=WEEvREcwSlJHSldTTEYzVDhUSFJNSUhOejRmRHJMQm9ZZzhUUUtlSHE2RT0=$9A4hF_YAuvQ5obgVAqNKPCYcEjKensW4IQMovwHtwkF4VYPoHbKxJw!!&v=MjQ0MTRuZ1VydktOajNBWkxHNEg5ak1ySTlCWTRSOGVYMUx1eFlTN0RoMVQzcVRyV00xRnJDVVI3cWZiK1JyRnk=
六株人源益生菌的表面性质与黏附性能研究
熊世进,高文功,杨菲菲,赵雪婷,秦小彤,杜同浩,熊涛*
食品工业科技, 2019, 40(9): 126-132.
doi:10.13386/j.issn1002-0306.2019.09.023
官网链接:http://www.spgykj.com/PDF-nwe/2019/2019.9/19-9-126.pdf

六株益生菌的革兰氏染色(1000×)
Gram staining of six probiotics (1000×)
注:A~F分别对应发酵乳杆菌CECT5716、嗜酸乳杆菌 F-1、鼠李糖乳杆菌MP-108、长双歧杆菌BLI-02、乳双歧杆菌AD011及副干酪乳杆菌MP-137。
益生菌胞外蛋白与肠道粘膜免疫细胞互作关系的研究进展
臧凯丽,任效东,王秋萍,王泳,阎亚丽,赵培,赵林森,刘爱国*,陈庆森*
食品工业科技, 2018, 39(14): 346-351.
doi:10.13386/j.issn1002-0306.2018.14.065
官网链接:http://www.spgykj.com/PDF-nwe/2018/2018.14/18-14-346.pdf
具有抑制肠道致病菌和黏附Caco-2细胞作用的益生性乳酸菌的筛选及鉴定
张汝京,胡亚凡,海丹,赵梦娜,陆兆新,吕凤霞,赵海珍,张充,别小妹
食品工业科技, 2019,40(2): 133-139, 153.
doi:10.13386/j.issn1002-0306.2019.20.022
官网链接:http://www.spgykj.com/PDF-nwe/2019/2019.20/19-20-133.pdf
乳酸菌发酵上清液对沙门氏菌的生长抑制作用
Cell-free fermentation supernatants of lactic acid bacteria inhibit the growth of Salmonella
注:图左为鼠伤寒沙门氏菌;图右为肠炎沙门氏菌;牛津杯直径为8 mm。

五株乳酸菌对Caco-2细胞黏附能力的比较
Comparisons of adhesion ability of five lactic acid bacteria to Caco-2 cells
注:图A:C174对Caco-2细胞的黏附光学显微镜图(×1000);图B:D24对Caco-2细胞的黏附光学显微镜图(×1000);图C为五株乳酸菌黏附Caco-2细胞的平板计数;不同小写字母表示不同均值间存在显著性差异(P<0.05);LGG为对照菌株属于鼠李糖乳杆菌GG,保藏编号为ATCC53103。





